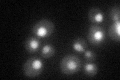
YBR152W
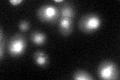
YBR152W
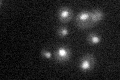
YBR152W

View description
mRNA splicing factor, component of U4/U6.U5 tri-snRNP; interacts genetically and physically with Prp38p
Localization:
Intensity:
Fold change:
Significance:
-
C’ GFP library in SD
nucleus32.45 -
N' NOP1pr-GFP in SD

nucleus51.0464 -
N' TEF2pr-mCherry in SD

missing0 -
N' NATIVEpr-GFP in SD

missing0 -
N' TEF2pr-VC and Cyto-VN in SD

#N/A0 -
C’ GFP library in SD+DTT
nucleus34.791.07No -
C’ GFP library in SD+H2O2

nucleus32.581No -
C’ GFP library in Starvation Media
nucleus27.640.85No -
C’ GFP library on the background of Pup2-DaMP

nucleus -
C’ GFP library on the background of CCT mutant

nucleus36.57741.12698No
